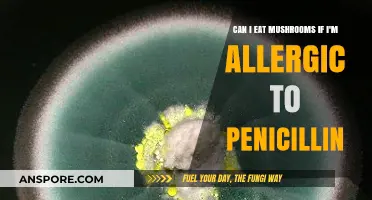
Mushroom Safety for Penicillin Allergy Sufferers: What You Need to Know

The FODMAP diet, designed to alleviate symptoms of irritable bowel syndrome (IBS), restricts certain carbohydrates that are poorly absorbed and can trigger digestive discomfort. When it comes to mushrooms, their suitability on a FODMAP diet depends on the type and portion size. Common varieties like button, cremini, and portobello mushrooms are generally considered low in FODMAPs and can be consumed in moderate amounts, typically up to 75 grams (or about ½ cup) per serving. However, exotic mushrooms such as shiitake or oyster mushrooms may contain higher FODMAP levels and should be approached with caution or avoided. As always, individual tolerance varies, so it’s advisable to monitor your body’s response and consult a dietitian for personalized guidance.
| Characteristics | Values |
|---|---|
| FODMAP Content | Mushrooms are generally considered low in FODMAPs in standard serving sizes (e.g., 75g or ½ cup raw/cooked). |
| Safe Varieties | Common mushrooms like button, cremini, portobello, shiitake, and oyster mushrooms are typically FODMAP-friendly. |
| Portion Size | Stick to small to moderate portions (e.g., 75g raw/cooked) to avoid potential FODMAP accumulation. |
| Preparation Methods | Cooking methods like sautéing, grilling, or baking are suitable. Avoid adding high-FODMAP ingredients (e.g., garlic, onion). |
| Potential Risks | Overconsumption or individual sensitivity may trigger symptoms in some people with IBS. |
| Diet Phase | Safe during the elimination and reintroduction phases of the low-FODMAP diet. |
| Certified Status | Many mushrooms are Monash University Certified as low-FODMAP in recommended servings. |
| Alternative Options | If intolerant, consider low-FODMAP vegetables like spinach, zucchini, or bell peppers as substitutes. |
Explore related products
$7.62 $14.95
What You'll Learn
- Low-FODMAP Mushroom Varieties: Identify mushrooms like oyster, shiitake, and button that are safe in small portions
- Portion Control Tips: Learn how to limit mushroom intake to avoid triggering FODMAP sensitivity symptoms
- High-FODMAP Mushrooms to Avoid: Steer clear of dried shiitake and large portions of button mushrooms
- Cooking Methods for Tolerance: Sautéing or grilling mushrooms may reduce FODMAP content, aiding digestion
- Symptom Monitoring Advice: Track reactions to mushrooms to personalize your FODMAP diet effectively

Low-FODMAP Mushroom Varieties: Identify mushrooms like oyster, shiitake, and button that are safe in small portions
Mushrooms can be a tricky territory for those following a low-FODMAP diet, but not all varieties are off-limits. Among the safest options are oyster, shiitake, and button mushrooms, which are generally well-tolerated in small portions. These mushrooms have lower levels of fermentable oligosaccharides, the FODMAP components that often trigger digestive discomfort. For instance, a serving size of 75 grams (about ½ cup) of raw button mushrooms is considered low-FODMAP, making them a versatile addition to meals without risking symptoms.
When incorporating oyster mushrooms into your diet, consider their delicate texture and mild flavor, which pairs well with stir-fries or soups. A 50-gram serving (about ⅓ cup) of raw oyster mushrooms is safe for most individuals on a low-FODMAP diet. However, portion control is key, as exceeding these amounts can increase the risk of symptom flare-ups. Shiitake mushrooms, known for their umami richness, are another excellent choice, with a recommended serving of 60 grams (about ½ cup) raw to stay within low-FODMAP limits.
For practical tips, start by sautéing button mushrooms with garlic-infused oil (a FODMAP-friendly alternative to raw garlic) for a flavorful side dish. When using shiitake mushrooms, slice them thinly and add to broths or noodle dishes for depth of flavor. Oyster mushrooms can be pan-fried until crispy and served as a topping for salads or grain bowls. Always measure portions to ensure compliance with low-FODMAP guidelines, especially during the elimination phase of the diet.
While these mushrooms are generally safe, individual tolerance can vary. If you’re new to the low-FODMAP diet, introduce one variety at a time and monitor your body’s response. Consulting a dietitian can provide personalized guidance, particularly if you have specific sensitivities or conditions like irritable bowel syndrome (IBS). By choosing the right mushrooms and adhering to portion sizes, you can enjoy their nutritional benefits and culinary versatility without compromising your dietary needs.
Mushroom Poison Absorption: Can Toxins Penetrate Skin on Contact?
You may want to see also

Portion Control Tips: Learn how to limit mushroom intake to avoid triggering FODMAP sensitivity symptoms
Mushrooms can be a tricky food for those following a low-FODMAP diet, as they contain varying levels of oligosaccharides, a type of fermentable carbohydrate that may trigger digestive symptoms. While some mushrooms, like oyster and shiitake, are considered low-FODMAP in small portions (approximately 75 grams or 1/2 cup), others, such as button and cremini, can be problematic in larger amounts. To safely include mushrooms in your diet without exacerbating FODMAP sensitivity, precise portion control is essential.
Step-by-Step Portion Control Strategy:
- Measure Accurately: Use a kitchen scale or measuring cups to ensure you stay within the recommended low-FODMAP portion size. For example, limit button mushrooms to 20 grams (about 2 medium mushrooms) per serving.
- Mix Mushroom Types: Combine low-FODMAP varieties like oyster or shiitake with smaller amounts of higher-FODMAP options to balance flavor and tolerance.
- Track Your Intake: Keep a food diary to monitor how different mushroom types and quantities affect your symptoms, identifying your personal threshold.
Cautions to Consider: Avoid mushroom-heavy dishes like creamy soups or stuffed mushrooms, as these often exceed safe portion sizes. Be wary of packaged mushroom products, which may contain added high-FODMAP ingredients like garlic or onion.
Practical Tips for Success: Incorporate mushrooms as a flavor enhancer rather than a main ingredient. For instance, sauté a small handful of shiitakes to add umami to stir-fries or omelets. Alternatively, use mushroom powders or extracts, which provide flavor without the FODMAP load.
By mastering portion control and making mindful choices, you can enjoy mushrooms as part of a low-FODMAP diet without triggering discomfort. Experiment cautiously, listen to your body, and adjust your intake to find the perfect balance for your digestive health.
Profitable Mushroom Farming: How to Earn Growing Gourmet Fungi
You may want to see also

High-FODMAP Mushrooms to Avoid: Steer clear of dried shiitake and large portions of button mushrooms
Dried shiitake mushrooms, a pantry staple in many kitchens, can be a hidden FODMAP trap. The dehydration process concentrates their naturally occurring oligosaccharides, a type of fermentable carbohydrate that triggers digestive discomfort in those with irritable bowel syndrome (IBS). A mere 10 grams of dried shiitake mushrooms, roughly equivalent to a heaped tablespoon, contains enough FODMAPs to exceed the recommended threshold for a low-FODMAP diet. This means that even a small garnish of dried shiitake in a stir-fry or soup could potentially lead to bloating, gas, or abdominal pain for sensitive individuals.
While fresh button mushrooms are generally considered low-FODMAP in small servings (around 75 grams or 5 medium mushrooms), portion size is crucial. The FODMAP content in button mushrooms increases significantly as the serving size grows. Consuming a large portobello mushroom cap, for example, which can weigh upwards of 150 grams, may push you into high-FODMAP territory. This is because the fructans, another type of FODMAP, accumulate in larger quantities in bigger mushrooms. For those following a strict low-FODMAP diet, it’s essential to measure portions carefully and opt for smaller, younger button mushrooms when possible.
The distinction between dried and fresh mushrooms highlights the importance of preparation methods in FODMAP management. Drying intensifies the FODMAP concentration in shiitake mushrooms, making them unsuitable for a low-FODMAP diet, whereas fresh shiitake mushrooms in moderate amounts (up to 50 grams) are generally well-tolerated. Similarly, button mushrooms can be enjoyed in small servings, but their FODMAP content escalates with size. This underscores the need for precision in both ingredient selection and portion control when incorporating mushrooms into a FODMAP-friendly meal plan.
For those navigating the complexities of a low-FODMAP diet, avoiding dried shiitake mushrooms and monitoring button mushroom portions are practical steps to prevent digestive distress. Substituting dried shiitake with fresh shiitake or other low-FODMAP mushrooms, such as oyster or enoki, can help maintain flavor without compromising gut health. Additionally, using smaller button mushrooms or slicing larger ones thinly can allow for inclusion in recipes while staying within safe FODMAP limits. By understanding these nuances, individuals with IBS can continue to enjoy mushrooms as part of a balanced and symptom-free diet.
Mushroom Pepper Pizza: A Type 2 Diabetes-Friendly Option?
You may want to see also
Explore related products
$9.73 $18.99

Cooking Methods for Tolerance: Sautéing or grilling mushrooms may reduce FODMAP content, aiding digestion
Mushrooms, while nutrient-dense, can pose challenges for those on a low-FODMAP diet due to their oligosaccharide content. However, cooking methods like sautéing or grilling have been shown to reduce FODMAP levels, making mushrooms more digestible. This transformation occurs because heat breaks down complex carbohydrates, minimizing the compounds that trigger gastrointestinal discomfort. For individuals with irritable bowel syndrome (IBS) or similar conditions, this simple adjustment can mean the difference between enjoying mushrooms and avoiding them entirely.
To maximize FODMAP reduction, start by slicing mushrooms thinly and heating them in a pan over medium-high heat. Use a small amount of oil or cooking spray to prevent sticking, and cook until they are golden brown and slightly crispy. This process not only enhances flavor but also concentrates the mushroom’s natural umami, making them a versatile addition to meals. Grilling achieves similar results, especially when mushrooms are cooked directly on a hot grill for 5–7 minutes per side. Both methods ensure that mushrooms retain their nutritional benefits while becoming gentler on the digestive system.
A comparative analysis of raw versus cooked mushrooms highlights the effectiveness of these techniques. Raw mushrooms contain higher levels of oligosaccharides, which can ferment in the gut and cause bloating or gas. In contrast, sautéed or grilled mushrooms have significantly lower FODMAP content, often falling within safe limits for low-FODMAP diets. Studies suggest that cooking reduces FODMAPs by up to 30–40%, depending on the mushroom variety and cooking duration. For example, button mushrooms, when sautéed, become a more tolerable option for those with sensitive digestive systems.
Practical tips for incorporating cooked mushrooms into a low-FODMAP diet include pairing them with lactose-free cream or garlic-infused oil for added flavor without FODMAP overload. Portion control is also key; Monash University recommends a maximum serving of 75 grams (about ½ cup) of cooked mushrooms per meal to stay within FODMAP thresholds. Experimenting with varieties like portobello or shiitake can add diversity, though always check their specific FODMAP profiles. By mastering these cooking methods, individuals can enjoy mushrooms as part of a balanced, gut-friendly diet.
Mushrooms and Ulcerative Colitis: Safe to Eat or Risky Choice?
You may want to see also

Symptom Monitoring Advice: Track reactions to mushrooms to personalize your FODMAP diet effectively
Mushrooms are a gray area in the FODMAP diet, with some varieties considered low-FODMAP in small portions (e.g., 1 cup raw or ½ cup cooked button mushrooms) and others potentially triggering symptoms due to their oligosaccharide content. To navigate this, symptom monitoring becomes your compass. Start by introducing mushrooms in isolation—avoid pairing them with other high-FODMAP foods—and track your body’s response over 24–48 hours. Use a food and symptom diary to log details like portion size, mushroom type, and any gastrointestinal reactions (bloating, gas, pain). This data will reveal your personal tolerance threshold, allowing you to adjust intake without relying on generic guidelines.
Analyzing your tracking data requires a critical eye. If symptoms occur after consuming mushrooms, consider whether the portion exceeded low-FODMAP limits or if the variety (e.g., shiitake, portobello) is higher in FODMAPs. Cross-reference your findings with reputable FODMAP databases to identify patterns. For instance, repeated reactions to larger portions might indicate a need to stick to smaller servings or avoid mushrooms altogether. Conversely, if no symptoms appear, experiment with slightly larger amounts to test your limits. This iterative process transforms guesswork into a personalized strategy, ensuring mushrooms either remain on your plate or are removed with confidence.
Persuasive as it may be to rely on broad FODMAP rules, the reality is that individual tolerance varies widely. Symptom monitoring empowers you to reclaim control over your diet. For example, someone with mild IBS might tolerate 1 cup of cooked oyster mushrooms daily, while another may only manage ½ cup twice a week. By tracking reactions, you avoid unnecessary restrictions and maximize dietary variety. This approach also fosters mindfulness, as you become attuned to how your body responds to specific foods, a skill that extends beyond mushrooms to other FODMAP-containing items.
To streamline your tracking, adopt practical tools like smartphone apps with symptom-tracking features or a simple notebook divided into columns for date, food, portion, and reaction. Include details like meal timing and stress levels, as these can influence IBS symptoms. For instance, note whether mushrooms caused bloating after a rushed lunch versus a relaxed dinner. Over time, this granular data will highlight not just *what* triggers you, but *when* and *how*. Armed with this insight, you can fine-tune your FODMAP diet to include mushrooms in a way that aligns with your unique needs, turning a restrictive plan into a flexible, sustainable lifestyle.
Can Prairie Dogs Safely Eat Mushrooms? A Dietary Guide
You may want to see also
Frequently asked questions
Yes, most common mushrooms like button, cremini, portobello, shiitake, and oyster mushrooms are low in FODMAPs and can be eaten in moderate portions on a FODMAP diet.
While most mushrooms are low in FODMAPs, some varieties like enoki mushrooms may contain higher FODMAP levels in large amounts. It’s best to consume them in small portions or avoid if they trigger symptoms.
A low-FODMAP serving size is typically around 1 cup (75g) of cooked mushrooms. Stick to this portion to avoid potential digestive discomfort.